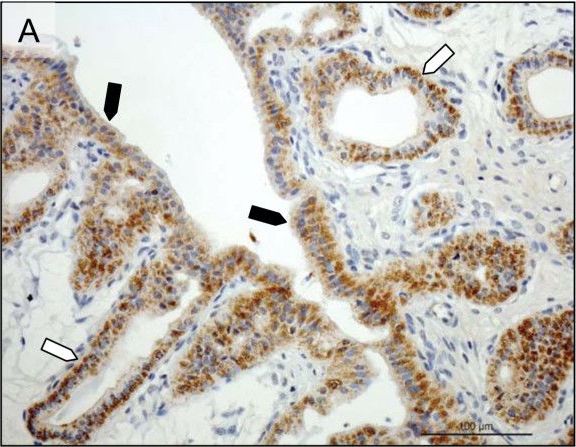
Detection of Canine Prolactin R by Immunohistochemistry

Human Prolactin R Antibody
R&D Systems, part of Bio-Techne | Catalog # AF1167


Key Product Details
Species Reactivity
Validated:
Cited:
Applications
Validated:
Cited:
Label
Antibody Source
Product Specifications
Immunogen
Gln25-Asp234
Accession # P16471
Specificity
Clonality
Host
Isotype
Scientific Data Images for Human Prolactin R Antibody
Detection of Human Prolactin R by Western Blot.
Western blot shows lysates of MCF-7 human breast cancer cell line, MDA-MB-453 human breast cancer cell line, and MDA-MB-468 human breast cancer cell line. PVDF membrane was probed with 1 µg/mL of Goat Anti-Human Prolactin R Antigen Affinity-purified Polyclonal Antibody (Catalog # AF1167) followed by HRP-conjugated Anti-Goat IgG Secondary Antibody (Catalog # HAF017). A specific band was detected for Prolactin R at approximately 95 kDa (as indicated). This experiment was conducted under reducing conditions and using Immunoblot Buffer Group 1.Detection of Canine Prolactin R by Immunohistochemistry
Immunohistochemical (IHC) localization of PRLr in the uterus pre-implantation and in the utero/placental compartment. (A, B) IHC localization of PRLr in canine endometrium at the pre-implantation stage of pregnancy. (C, D) IHC localization of PRLr within the utero/placental compartment (mid-gestation). (E, F) Localization of PRLr-mRNA in utero/placental compartment by in situ hybridization (ISH).(A, B) Pre-implantation PRLr is localized to the endometrial surface epithelial cells (solid arrowheads) and glandular epithelial cells of the superficial (open arrowheads) and deep (solid arrows) uterine glands. (C, D) Within the utero/placental compartment signals are localized to the endometrial glands including the superficial glands (solid arrowheads) (the so-called glandular chambers) and to the fetal trophoblast cells (open arrows). (E, F) The same localization pattern was observed at the mRNA-level by ISH. Thus, strong signals are localized to the trophoblast cells (open arrows) including those strongly invading maternal blood vessels at the base of placental labyrinth (open arrows). Image collected and cropped by CiteAb from the following open publication (https://rbej.biomedcentral.com/articles/10.1186/1477-7827-9-109), licensed under a CC-BY license. Not internally tested by R&D Systems.Detection of Canine Prolactin R by Immunohistochemistry
Immunohistochemical (IHC) localization of PRLr in the uterus pre-implantation and in the utero/placental compartment. (A, B) IHC localization of PRLr in canine endometrium at the pre-implantation stage of pregnancy. (C, D) IHC localization of PRLr within the utero/placental compartment (mid-gestation). (E, F) Localization of PRLr-mRNA in utero/placental compartment by in situ hybridization (ISH).(A, B) Pre-implantation PRLr is localized to the endometrial surface epithelial cells (solid arrowheads) and glandular epithelial cells of the superficial (open arrowheads) and deep (solid arrows) uterine glands. (C, D) Within the utero/placental compartment signals are localized to the endometrial glands including the superficial glands (solid arrowheads) (the so-called glandular chambers) and to the fetal trophoblast cells (open arrows). (E, F) The same localization pattern was observed at the mRNA-level by ISH. Thus, strong signals are localized to the trophoblast cells (open arrows) including those strongly invading maternal blood vessels at the base of placental labyrinth (open arrows). Image collected and cropped by CiteAb from the following open publication (https://rbej.biomedcentral.com/articles/10.1186/1477-7827-9-109), licensed under a CC-BY license. Not internally tested by R&D Systems.Applications for Human Prolactin R Antibody
Immunohistochemistry
Sample: Immersion fixed paraffin-embedded sections of human breast
Western Blot
Sample: MCF‑7 human breast cancer cell line, MDA‑MB‑453 human breast cancer cell line, and MDA‑MB‑468 human breast cancer cell line
Formulation, Preparation, and Storage
Purification
Reconstitution
Formulation
Shipping
Stability & Storage
- 12 months from date of receipt, -20 to -70 °C as supplied.
- 1 month, 2 to 8 °C under sterile conditions after reconstitution.
- 6 months, -20 to -70 °C under sterile conditions after reconstitution.
Background: Prolactin R
The neuroendocrine pituitary hormone Prolactin (PRL), also known as lactotrophin, mamotrophin, luteotropic hormone (LTH), or luteotropin, is a secreted hormone that affects reproduction and homeostasis in vertebrates. The functions of PRL can be placed in six broad categories: 1) reproduction and lactation; 2) growth and development; 3) endocrinology and metabolism; 4) brain and behavior; 5) immunomodulation; and 6) electrolyte balance (1, 2). PRL is secreted by the anterior pituitary gland, mammary gland, placenta, brain, uterus, decidua, dermal fibroblasts, B cells, T cells, NK cells, and some breast cancer cell lines. Although the major form of PRL is a 23 kDa monomeric protein, splice variants of 14, 16, and 22 kDa have been identified. PRL has also been found to be glycosylated, phosphorylated, dimerized, and polymerized. Glycosylation, phosphorylation, dimerization, or polymerization of PRL result in lower activity (2).
Cell activation by PRL is mediated by a single chain membrane-bound protein belonging to the class 1 cytokine superfamily. The PRL receptor (PRL R) contains an extracellular, transmembrane, and intracellular domain. Transcriptional regulation of the PRL R gene results in several different species-dependent isoforms of PRL R being produced. Although the cytoplasmic domains of the different isoforms vary in length and composition, their extracellular domains are identical. In rats, three major PRL receptor isoforms have been described, a short (291 amino acid), an intermediate (393 amino acid), and a long (591 amino acid) (2). PRL receptors are found in mammary tissue, pituitary gland, brain, heart, lung thymus, spleen, liver, pancreas, kidney, adrenal gland, uterus, skeletal muscle, and skin (3). A soluble form of PRL-R containing the 206 NH2-terminal amino acids of the extracellular domain is secreted by mammary epithelial cells and is found in milk. Binding of the transmembrane PRL R results in ligand dimerization followed by binding and phosphorylation of Jak2. Jak2 then phosphorylates STAT and the long form of PRL R. C‑src, fyn, and the Ras/Raf/MAP kinase pathway have also been found to be activated upon PRL R ligand binding (2).
References
- Kelly, P.A. et al. (2001) Biochem. Society Transaction 29:48.
- Freeman, M.E. et al. (2000) Physiol. Rev. 80:1532.
- Nagano, M. and P.A. Kelly (1994) J. Biol. Chem. 269:13337.
Long Name
Alternate Names
Gene Symbol
UniProt
Additional Prolactin R Products
Product Documents for Human Prolactin R Antibody
Product Specific Notices for Human Prolactin R Antibody
For research use only